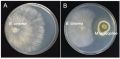
��� ������������ ������� �������� �� ������� ��������

Жители тюменского СНТ "Россиянка" получат дополнительное электроснабжение
Решение принято на региональном штабе по обеспечению безопасности электроснабжения.
В случае аварии на сетях, потребители в товариществе будут запитаны от двух генераторов суммарной мощностью почти 1000 кВА до устранения повреждения.
В Тюменской области в резерве находятся 310 источников электроснабжения, которые могут быть применены при аварийных отключениях.